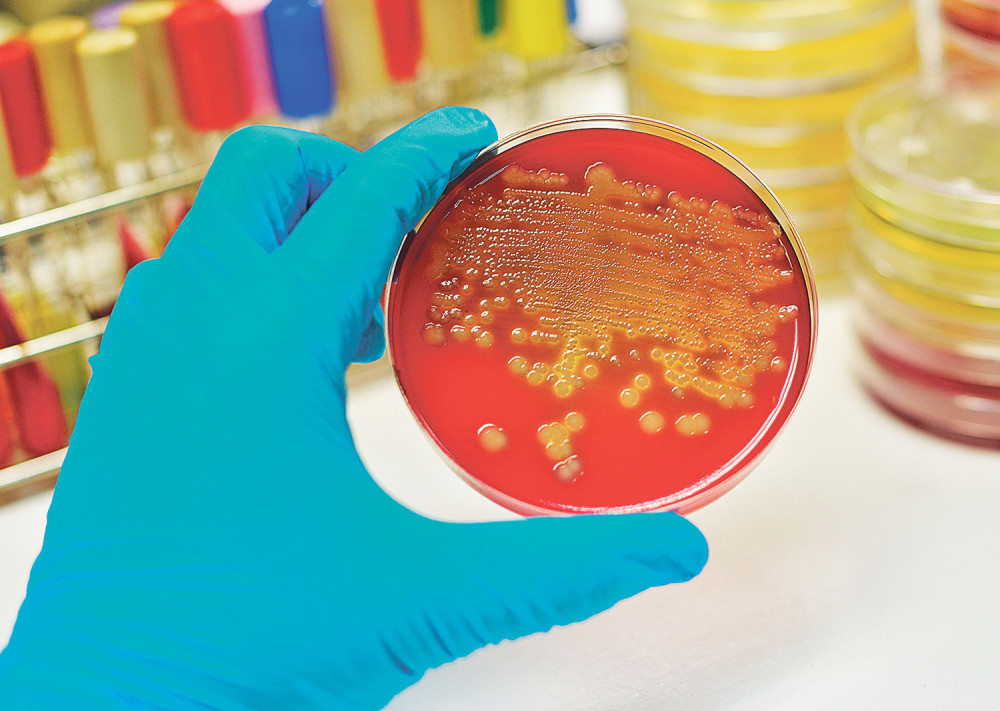
Prvi slučaj gonoreje otporne na sve antibiotike!

Tema: polne bolesti
 DOKTOR BJEKIĆ OBELODANIO
DOKTOR BJEKIĆ OBELODANIO
Srbijom ne hara samo korona, već i jedna polna bolest (VIDEO)
 SVE VIŠE OBOLELIH U SRBIJI
SVE VIŠE OBOLELIH U SRBIJI
Seksualno prenosiva bolest hara u vreme korone (VIDEO)

Seksualno prenosiva bolest koju možda imate, a ne znate!
 OPREZ!
OPREZ!
Iako koristite kondom, ipak možete dobiti ove polne bolesti
 ALARMANTNA SITUACIJA
ALARMANTNA SITUACIJA
Sve više oboljevamo od sifilisa i gonoreje
 ZABRINJAVAJUĆE
ZABRINJAVAJUĆE
Gadna polna bolest hara Srbijom, broj obolelih se utrostručio!
ZVANIČNO POTVRĐENO
ZVANIČNO POTVRĐENO
Prvi slučaj gonoreje otporne na sve antibiotike!
 AUUU!
AUUU!
Oralni seks je sve češći uzrok raka grla! (ANKETA)
 ALARMANTNO
ALARMANTNO
U Srbiji se godišnje uradi 60.000 abortusa!
 I BEZ SEKSA
I BEZ SEKSA
Ovde možete nahvatati polne bolesti!
 ŠTA SI OPALIO, OPALIO SI
ŠTA SI OPALIO, OPALIO SI
Varao na sve strane, pa mu žena "zabiberila"...
 UPS...
UPS...
Brijanjem stidnih dlačica rizikujete zdravlje!
 UPOZORENJE LEKARA
UPOZORENJE LEKARA
Gonoreja postaje neizlečiva bolest!
 JELENA GOLUBOVIĆ ZA ALO!
JELENA GOLUBOVIĆ ZA ALO!





























Bio mi je prvi! Ubrzo sam saznala da imam 3 polne bolesti, ali najgore me tek sačekalo...